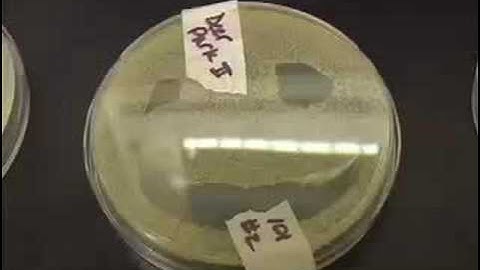
Introduction to Engineering Design

⬇ DOWNLOAD NOW
Kalau muncul iklan pop-up, tutup lalu klik tombol kembali
Download lagu ENGG1000 Introduction to Engineering Design and Innovation secara gratis hanya untuk keperluan promosi. Dukung artis favorit kamu dengan membeli musik original di iTunes atau platform resmi lainnya.
Introduction to Engineering Design
Introduction to Engineering Design
 FSE 100 - Introduction to Engineering Course Overview
FSE 100 - Introduction to Engineering Course Overview
 Introduction to Engineering and Design
Introduction to Engineering and Design
 ENGG1000 - Final Design Simulation
ENGG1000 - Final Design Simulation
 Engineering Design and Innovation Showcase
Engineering Design and Innovation Showcase
 ENGG1000 Energy From Waves Trailer
ENGG1000 Energy From Waves Trailer
 Engineering Design Process
Engineering Design Process
 Study Engineering Design Technology at NAIT
Study Engineering Design Technology at NAIT